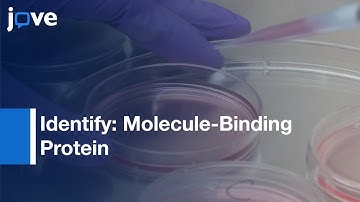
Live-cell Photoaffinity Labeling:Binding Proteins (Native Environment)

⬇ DOWNLOAD NOW
Kalau muncul iklan pop-up, tutup lalu klik tombol kembali
Download lagu Binding Proteins of Small Ligands Identification with DRaCALA | Protocol Preview secara gratis hanya untuk keperluan promosi. Dukung artis favorit kamu dengan membeli musik original di iTunes atau platform resmi lainnya.
 Mass Spectrometry-based Identification of RNA-binding Regions | Protocol Preview
Mass Spectrometry-based Identification of RNA-binding Regions | Protocol Preview
 Refolding & Purification (Method):Chemoreceptor Ligand Binding Domain
Refolding & Purification (Method):Chemoreceptor Ligand Binding Domain
 Atomistic simulation of a complete protein-peptide binding pathway with rigorous kinetics
Atomistic simulation of a complete protein-peptide binding pathway with rigorous kinetics
 PyMOL ligand-protein interactions | PyMOL tutorial | Protein Data Bank | Basic Science Series
PyMOL ligand-protein interactions | PyMOL tutorial | Protein Data Bank | Basic Science Series
 Identifying Small Molecule Inhibitors Of Protein-Protein Interaction-Preview
Identifying Small Molecule Inhibitors Of Protein-Protein Interaction-Preview
Live-cell Photoaffinity Labeling:Binding Proteins (Native Environment)
Live-cell Photoaffinity Labeling:Binding Proteins (Native Environment)
 Time-lapse of automated kinase inhibitor fluorescence binding assay
Time-lapse of automated kinase inhibitor fluorescence binding assay
 Intro to Cell Signaling
Intro to Cell Signaling